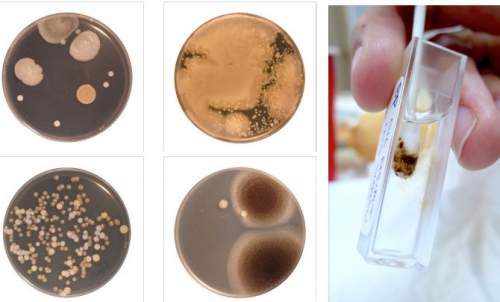

Hijyen faktörü, sağlık açısından oldukça önemlidir. Bunu hemen herkes bilir. Temiz bir vücuda sahip olmak ve ona iyi bakmak bizim için çok önemlidir. Çünkü kirli ortamlarda bakteri çeşidi daha fazladır. Bu nedenle olası yaralanmalarda inflamasyon (iltihap) riski çok daha fazla olur. Ancak ne kadar temizlesek de bazı noktalar hala kirli kalabiliyor veya bu noktaların daha fazla ve dikkatli temizlenmesi gerekebiliyor. Peki hiç merak ettiniz mi, vücudumuzun en kirli yeri neresidir?
Vücudumuzun En Kirli Yeri
Vücudun farklı noktalardan alınan numunelerin karşılaştırılmasını esas alan bir araştırma, biz insanlara vücudumuzun en kirli yeri hakkında bilgi veriyor. Araştırma sonuçlarına göre ne kadar temizlesek de göbek deliğimizde kir kaldığı yönünde. Ayrıca temizlik sırasında pek çok kişinin de önem göstermediğini düşündüğümüzde bu miktar katlanarak artmakta. Birçok dermatolog, göbek deliği temizliğinin hayati önem taşıdığı düşüncesinde hem fikir olmuş durumda. Bu yüzden temizlik sırasında göbek deliğinin de temizliğe dahil edilmesi gerektiği konusunda şiddetle uyarıda bulunuyorlar.
Göbek Deliği Nasıl Kirlenir?
Gün içerisinde kir, yağ, ölmüş deri, nem gibi faktörler ile göbek deliği kirlenebilir. Her ne kadar duşta ovalamak yeterli gibi görülse de göbek deliği temizliği için duş yeterli değildir. Bakterilerin yaşaması ve üremesi için oldukça elverişli olan bu ortamın temizliğine dikkat etmek gerektiğinden, temizlik itinayla yapılmalıdır. Uzun süre temizlenmediğinde oldukça fazla birikme ortaya çıkabilir. Sağlık açısından çok önemli olan bu temizlik kesinlikle ihmal edilmemelidir.
Göbek Deliği Nasıl Temizlenir?
Göbek deliği temizliği için duşta ovalama ne yazık ki yeterli değildir. Dermatologlar daha özenli bir temizlik gerektiği düşüncesinde hemfikirdirler. Göbek deliğiniz temizlemek için genelde iki yol uygun görülmektedir.
- Tuzlu Su: Bir çay kaşığı kadar tuzu 200 ml kadar hacme sahip su bardağında çözün. Suyun ılık olmasına ve tuzun iyice çözündüğüne dikkat edin. Ardından da parmağınızla veya pamuklu çubukla bu çözeltiden bir miktar alıp göbek deliğinizi ovalayın. Daha sonra tuzsuz su yardımıyla iyice durulayın. Burada da herhangi bir kalıntı kalmadığından emin olun. Uzmanlar, genellikle bu yolun göbek deliğinden koku geldiğinde etkili bir temizlik için kullanılabileceğini belirtiyor.
- Sürtünme Alkolü: Pamuklu çubuk ile birlikte bu yöntemi kullanabilirsiniz. Sürtünme alkolüne pamuklu çubuğu batırıp göbek deliğinize hafifçe sürün. Tamamen temizlendiğinden emin oluncaya kadar bu adımı tekrarlamanızda yarar var.

Koşu Ayakkabısı Seçerken Dikkat Edilmesi Gereken 5 Faktör
E-Fatura Kontör Nedir ve Nasıl Çalışır?
New Balance 574 Ayakkabı Modeli ile Tarzınızı Konuşturun
Pawpaw Mama Nasıl?